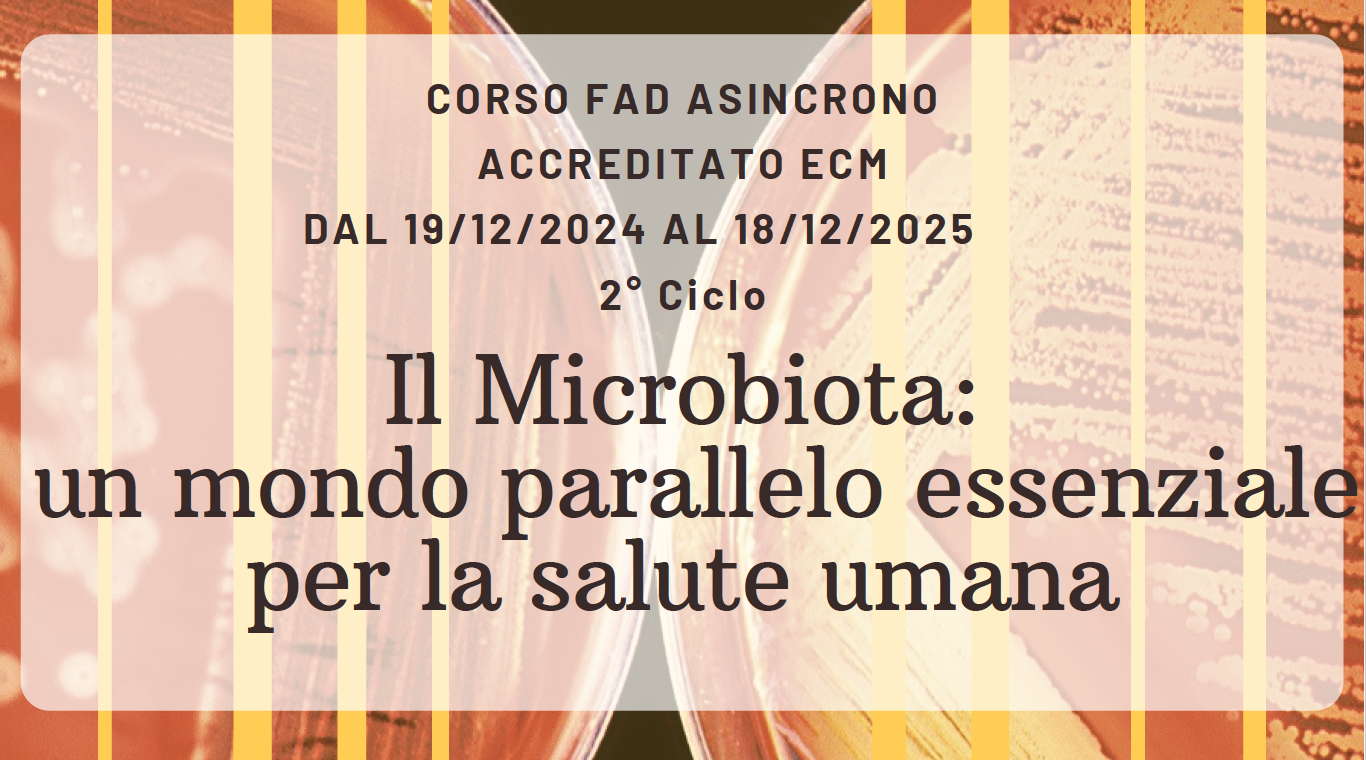
19/12/25 - 18/12/2025_OBTU_SO2633
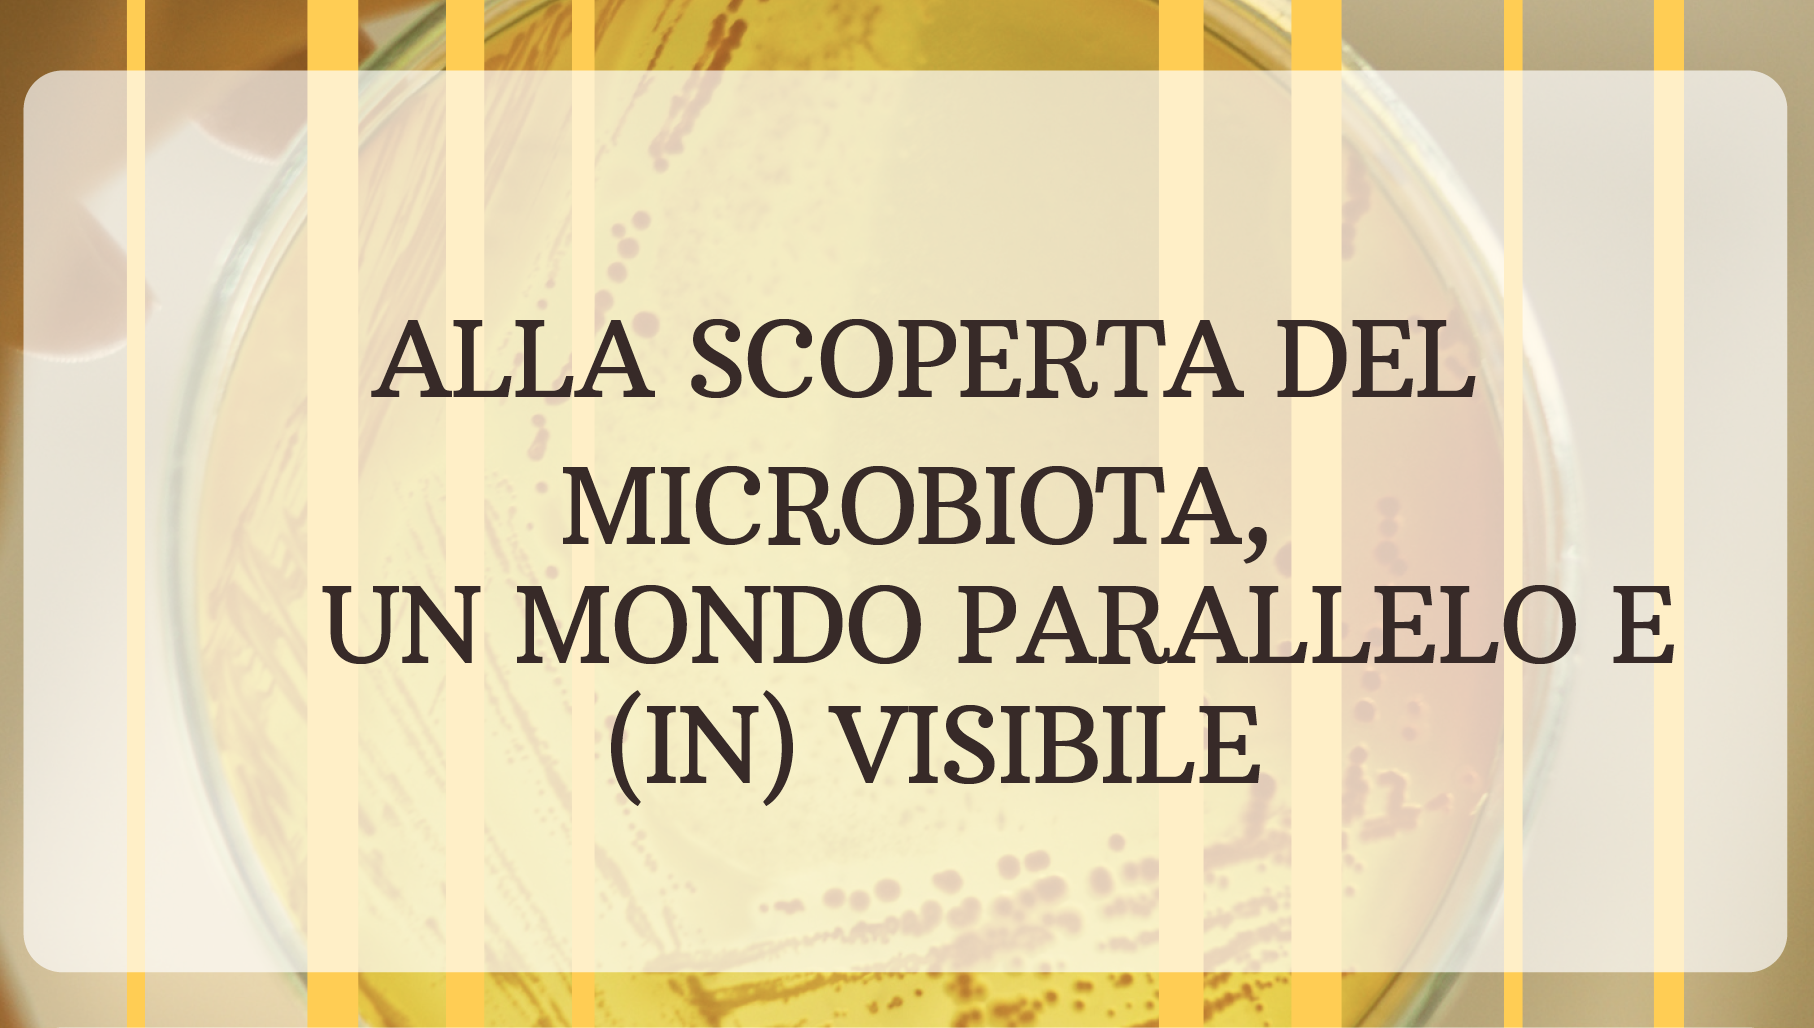
05/10/2024-04/10/2025_OBTU_SO2510

Date: 10/06/2025 - 10/07/2025
Ore Totali: 56 • Scarica programma dettagliato
Tipologia FAD: Asincrona
N° Partecipanti: 50
ECM: ID 454461 - crediti n° 50
Destinatari: MEDICO CHIRURGO (Psichiatria, Psicoterapia); PSICOLOGO (Psicologia, Psicoterapia).
Responsabili Scientifici: Camillo Loriedo
Obiettivo formativo: n° 18
Modalità fruizione corso: Scarica
Date: 20/03/2025 - 31/12/2025
Ore Totali: 34 • Scarica programma dettagliato
Tipologia FAD: Asincrona
N° Partecipanti: 100
ECM: ID 445426 - crediti n° 50
Destinatari: MEDICO CHIRURGO (Tutte le discipline); PSICOLOGO (Psicologia, Psicoterapia); FARMACISTA (Tutte le discipline); ASSISTENTE SANITARIO; EDUCATORE PROFESSIONALE; FISIOTERAPISTA; INFERMIERE; INFERMIERE PEDIATRICO; LOGOPEDISTA; TECNICO DELLA RIAB. PSICHIATRICA; TERAPISTA DELLA NEURO E PSICOMOTRICITÀ DELL’ETÀ EVOLUTIVA; TERAPISTA OCCUPAZIONALE; FISIOTERAPISTA; ODONTOIATRA; VETERINARIO (Tutte le discipline).
Responsabile Scientifico: Maddalena Genco
Obiettivo formativo: n° 3
COSTO:
SUMMER SALE: € 297,00 fino al 30/06
€ 427,00 per chi si iscrive entro dopo il 30/04/2025
Data: da definire
• Scarica programma dettagliato
Tipologia FAD: Asincrona
ECM: crediti n° 50
Destinatari: Biologi, Chimici, Tecnici della prevenzione nell’ambiente e nei luoghi di lavoro
Responsabili Scientifici: Gian Franco Gaggino
COSTI E MODALITÀ DI PAGAMENTO
Info e richieste: Formazione@nadei.it
Date: 24/02/2025 - 31/12/2025
Tipologia FAD: Asincrona
Scarica il programma dettagliato
ECM: crediti n° 50
Destinatari: MEDICO CHIRURGO (tutte le discipline)
Responsabile Scientifico: Enrica Maggiori
Obiettivo formativo: Medicine non convenzionali: valutazione dell'efficacia in ragione degli esiti e degli ambiti di complementarietà
Modalità fruizione corso: Scarica
Quota d'iscrizione: Non soci SIM: € 488,00 fino al 15/04/2025, a partire dal 16/04/2025 € 693,00. Soci SIM: € 305,00
per info e richieste info@qibli.it
Date: 17/02/2025 - 31/12/2025
Ore Totali: 28 • Scarica programma dettagliato
Tipologia FAD: Asincrona
N° Partecipanti: 300
ECM: ID 442180 - crediti n° 42
Destinatari: MEDICO CHIRURGO (Chirurgia generale, Neurologia, Neuropsichiatria Infantile, Psichiatria, Psicoterapia); FARMACISTA (Tutte le discipline); PSICOLOGO (Psicologia, Psicoterapia); INFERMIERE; TECNICO DELLA RIABILITAZIONE PSICHIATRICA.
Responsabili Scientifici: Alessandro Carmelita
Obiettivo formativo: n° 3
Modalità fruizione corso: Scarica
Date: 17/02/2025 - 31/12/2025
Ore Totali: 28 • Scarica programma dettagliato
Tipologia FAD: Asincrona
N° Partecipanti: 300
ECM: ID 442182 - crediti n° 28
Destinatari: MEDICO CHIRURGO (Chirurgia Generale, Neurologia, Neuropsichiatria Infantile, Psichiatria, Psicoterapia, Scienza dell’Alimentazione e Dietetica); PSICOLOGO (Psicologia, Psicoterapia); ASSISTENTE SANITARIO; DIETISTA; FISIOTERAPISTA; INFERMIERE; LOGOPEDISTA.
Responsabili Scientifici: Alessandro Carmelita
Obiettivo formativo: n° 3
Modalità fruizione corso: Scarica
Date: 01/01/2025 - 31/12/2025
Ore Totali: 18 •Scarica programma dettagliato
Tipologia: FAD Asincrona
N° Partecipanti: 200
ECM: ID 438698 - crediti n° 27
Destinatari: BIOLOGO.
Obiettivo formativo: n° 2
Modalità fruizione corso: Scarica
COSTO: € 15,00
SCARICA BROCHURE
Date: 1 Gennaio 2025 - 31 Dicembre 2025
Ore Totali: 34 • Scarica programma dettagliato
Tipologia FAD: Asincrona N° Partecipanti: 120
ECM: ID 437606 - crediti n° 50
Destinatari: MEDICO CHIRURGO (Psichiatria, Psicoterapia); PSICOLOGO (Psicologia, Psicoterapia).
Responsabili Scientifici: Camillo Loriedo
Obiettivo formativo: n° 3
COSTI: 300,00
Modalità fruizione corso: Scarica
Date: 1 Gennaio 2025 - 31 Dicembre 2025
Ore Totali: 41 • Scarica programma dettagliato
Tipologia FAD: Asincrona N° Partecipanti: 500
ECM: ID 403831 - crediti n° 50
Destinatari: MEDICO CHIRURGO (Tutte le discipline); FARMACISTA (Tutte le discipline); ODONTOIATRA; BIOLOGO; DIETISTA.
Responsabili Scientifici: Ilaria Bertini, Chiara Priante
Obiettivo formativo: n° 3
COSTI: 300,00
Modalità fruizione corso: Scarica
Date: 01/01/2025 - 31/12/2025
Ore Totali: 39 • Scarica programma dettagliato
Tipologia FAD: Asincrona
N° Partecipanti: 200
ECM: ID 438174 - crediti n° 50
Destinatari: MEDICO CHIRURGO (Neurologia, Neuropsichiatria Infantile, Psichiatria, Chirurgia Generale, Neurochirurgia, Medicina Generale, Psicoterapia); PSICOLOGO (Psicologia, Psicoterapia); DIETISTA; FISIOTERAPISTA; EDUCATORE PROFESSIONALE; INFERMIERE; LOGOPEDISTA; TECNICO DELLA RIABILITAZIONE PSICHIATRICA.
Responsabili Scientifici: Alessandro Carmelita
Obiettivo formativo: n° 3
Modalità fruizione corso: Scarica
Date: 01/01/2025 - 31/12/2025
Ore Totali: 32 • Scarica programma dettagliato
Tipologia FAD: Asincrona
N° Partecipanti: 300
ECM: ID 437572 - crediti n° 32
Destinatari: MEDICO CHIRURGO (Chirurgia generale, Medicina Generale, Neurologia, Neuropsichiatria infantile, Psichiatria, Psicoterapia, Scienza dell’alimentazione e dietetica); FARMACISTA (Tutte le discipline); PSICOLOGO (Psicologia, Psicoterapia); DIETISTA; INFERMIERE; FISIOTERAPISTA; EDUCATORE PROFESSIONALE; LOGOPEDISTA; TECNICO DELLA RIABILITAZIONE PSICHIATRICA.
Responsabili Scientifici: Alessandro Carmelita
Obiettivo formativo: n° 3
Modalità fruizione corso: Scarica
Date: 19 Dicembre 2024 - 18 Dicembre 2025
Ore Totali: 8 • Scarica programma dettagliato
Tipologia FAD: Asincrona
N° Partecipanti: 200
ECM: ID 436948- crediti n° 18
Destinatari: BIOLOGO.
Responsabile Scientifico: Annalisa Olivotti
Obiettivo formativo: n° 18
COSTI: 15,00
Modalità fruizione corso: Scarica
Date: 1 Gennaio 2025 - 31 Dicembre 2025
Ore Totali: 2 • Scarica programma dettagliato
Tipologia FAD: Asincrona
N° Partecipanti: 100
ECM: ID 437006- crediti n° 15
Destinatari: MEDICO CHIRURGO (Neuropsichiatria Infantile, Pediatria),
PSICOLOGO (Psicologia). TERAPISTA DELLA NEURO E PSICOMOTRICITA’ DELL’ETA’
EVOLUTIVA; LOGOPEDISTA.
Responsabile Scientifico: Silvia Lanfranchi, Monica Rea
Obiettivo formativo: n° 18
COSTI: 300,00
Modalità fruizione corso: Scarica
Date: 25/11/2024 - 24/11/2025
Ore Totali: 34 • Scarica programma dettagliato
Tipologia FAD: Asincrona
N° Partecipanti: 300
ECM: ID 434962 - crediti n° 50
Destinatari: MEDICO CHIRURGO (Chirurgia generale, Medicina Generale, Neurologia, Neuropsichiatria infantile, Psichiatria, Psicoterapia, Scienza dell’alimentazione e dietetica); FARMACISTA (Tutte le discipline); PSICOLOGO (Psicologia, Psicoterapia); DIETISTA; INFERMIERE; FISIOTERAPISTA; EDUCATORE PROFESSIONALE; LOGOPEDISTA; TECNICO DELLA RIABILITAZIONE PSICHIATRICA.
Responsabili Scientifici: Alessandro Carmelita
Obiettivo formativo: n° 3
Modalità fruizione corso: Scarica
Date: 04/11/2024 – 03/11/2025
Ore Totali: 6 •Scarica programma dettagliato
Tipologia FAD: Asincrona
N° Partecipanti: 200
ECM: ID 433777 - crediti n° 9
Destinatari: BIOLOGO.
Obiettivo formativo: n° 2
Modalità fruizione corso: Scarica
COSTO: € 25,00
SCARICA BROCHURE
Date: 05/10/2024 - 04/10/2025
Ore Totali: 9 •Scarica programma dettagliato
Tipologia FAD: Asincrona
N° Partecipanti: 200
ECM: ID 430601 - crediti n° 19,5
Destinatari: BIOLOGO.
Obiettivo formativo: n° 2
Modalità fruizione corso: Scarica
COSTO: € 15,00
SCARICA BROCHURE
Date: 01/10/2024 - 30/09/2025
Ore Totali: 21 • Scarica programma dettagliato
Tipologia FAD: Asincrona
N° Partecipanti: 1000
ECM: ID 426846 - crediti n° 21
Destinatari: Medico Chirurgo (Oftalmologia).
Responsabili Scientifici: Romina Fasciani, Caterina Gagliano
Obiettivo formativo: n° 3
Modalità fruizione corso: Scarica
Date: 15/09/2024 - 14/09/2025
Ore Totali: 3 • Scarica programma dettagliato
Tipologia FAD: Asincrona
N° Partecipanti: 1000
ECM: ID 427206 - crediti n° 4,5
Destinatari: MEDICO CHIRURGO (Pediatria,
Pediatria (Pediatri di libera scelta), Allergologia ed Immunologia Clinica,
Dermatologia e Venereologia, Medicina Generale (Medici Di Famiglia),
Ginecologia e ostetricia); FARMACISTA (Farmacista territoriale)
Obiettivo formativo: n° 3